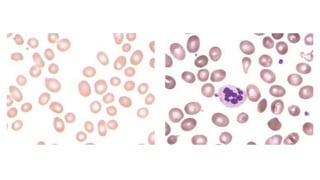
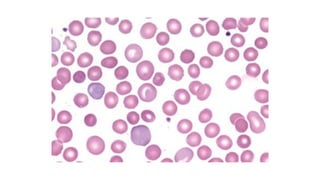
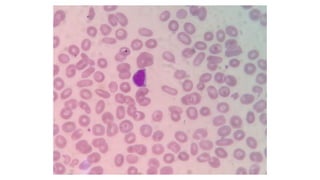

The document outlines the classification, clinical approach, causes, and treatments of various types of anemia, including iron deficiency anemia, megaloblastic anemia, and thalassemia. Key indicators for diagnosing anemia, such as hemoglobin levels and reticulocyte counts, are emphasized, along with differences in manifestations based on age and medical conditions. Effective treatment strategies are discussed, highlighting the importance of addressing underlying causes and the use of blood transfusions and supportive therapies.


![Normal Hb at sea level
Adult
Hb ≥ 13 g/dL in male
Hb ≥ 12 g/dL in female
Hb ≥ 11 g/dL in pregnancy
(10.5 in second trimester)
Pediatric
Hb ≥ 11 g/dL in 6 - 59 months
Hb ≥ 11.5 g/dL in 5 - 11 year
Hb ≥ 12 g/dL in 12-14 year
In newborn Hb is up to 14 g/dL and
gradually declines
WHO. 2011 (http://www.who.int/vmnis/indicators/haemoglobin. pdf, accessed [07/19/2018]).](https://image.slidesharecdn.com/commonanemia-190402165647/85/Common-anemia-3-320.jpg)